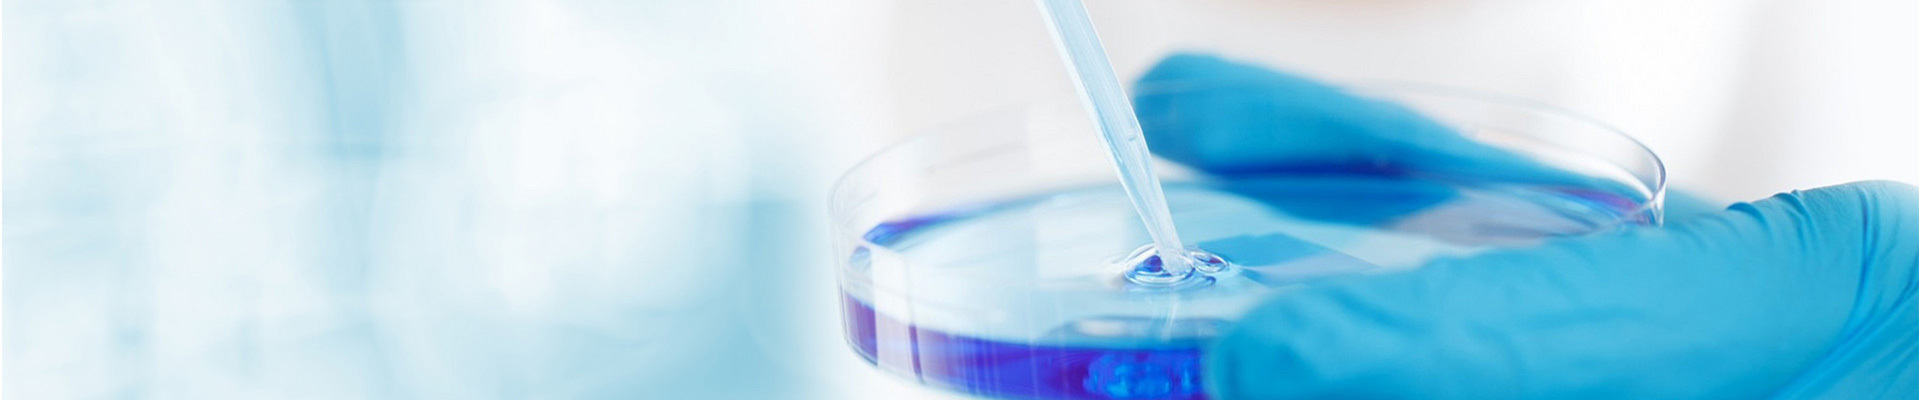
East Sunrise

Welcome to visit Shandong East Sunrise New Materials Co., Ltd!
Latest developments
2026/01/26
2026/01/26
2026/01/26
Contact Us
Address:8087 Longyang Road, Longshan Chemical Industry Park, Linqu County, Weifang City, Shandong Province,China
Product
Phone website
Copyright©2023 Shandong East Sunrise New Materials Co., Ltd.